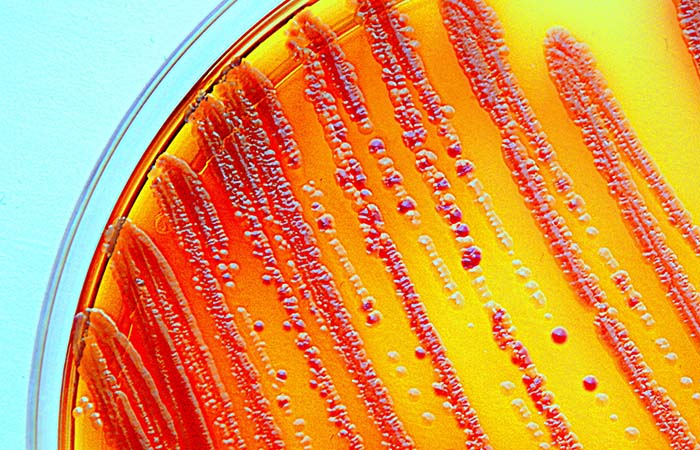

Bristol pharmacy secures grant funding to evaluate AMR solutions
In Health & NHS news
Follow this topic
Bookmark
Record learning outcomes
A Bristol pharmacy and university have secured grant funding for a four-month project to assess approaches to antimicrobial stewardship in a community pharmacy setting.
Award-winning Bedminster Pharmacy and UWE Bristol will use funding from the UK Research and Innovation’s (UKRI) regional fund to develop an “evidence-based approach for AMS that aims to revolutionise the traditional methods of service evaluation and development,” the university said.
The funding will allow Bedminster Pharmacy to evaluate its antibiotic prescribing and stewardship practises and “gain better insight about knowledge of antibiotics among their patients and their health seeking behaviour” according to a statement.
“The project is designed to overcome the limitations of conventional audits and customer feedback, offering a nuanced and date-driven perspective,” said UWE Bristol.
Bedminster Pharmacy superintendent pharmacist Ade Williams said: “The emerging role of community pharmacy offering timely accessible clinical interventions, including prescribing antibiotics, will undoubtedly help address the increasing demands on the NHS; it is also an exciting opportunity to embed evidence-based AMS principles and practice.
“Aligning these opportunities effectively is an important challenge to address, and I am grateful for this project.
“We are very excited working with the UWE to improve our pharmacy practice and combat antimicrobial resistance together.”
The project will be headed up by Emmanuel Adukwu, a principal investigator with the Centre for Research in Biosciences (CRIB), with post-doctoral researcher Obiageli Okolie coming on board as an associate.
Vincent Cheung, a community pharmacist and University of Bristol lecturer, said: “I am very impressed by the wealth of knowledge and experience brought by the UWE team. I am confident that they will provide an evidence-based solution to improve pharmacists’ knowledge and practice in the area.”